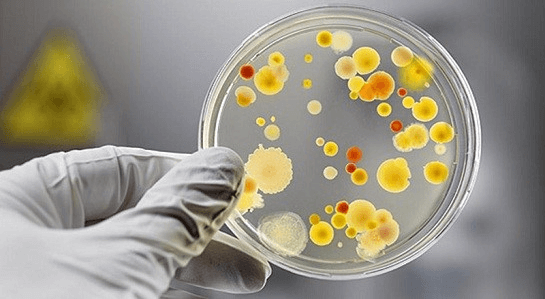

1. Khối B là gì? Những thay đổi trong các tổ hợp môn khối B hiện nay
Khối B là một trong những khối thi truyền thống trong kỳ thi đại học tại Việt Nam, được nhiều thí sinh lựa chọn do cơ hội nghề nghiệp rộng mở. Các môn thi truyền thống của khối B bao gồm Toán – Hóa – Sinh. Tuy nhiên, theo chương trình giáo dục phổ thông mới của Bộ Giáo dục & Đào tạo, từ năm 2025, kỳ thi tốt nghiệp THPT sẽ có những thay đổi đáng kể, ảnh hưởng đến các tổ hợp môn xét tuyển đại học, bao gồm khối B. Trước đây, khối B truyền thống bao gồm Toán – Hóa – Sinh, nhưng hiện nay, nhiều trường đại học đã mở rộng thêm các tổ hợp môn mới nhằm tạo điều kiện linh hoạt hơn cho thí sinh.
1. Các tổ hợp xét tuyển mới của khối B
Bên cạnh tổ hợp truyền thống B00 (Toán – Hóa – Sinh), nhiều trường đã áp dụng thêm các tổ hợp mở rộng như:
- B01: Toán – Sinh – Sử
- B02: Toán – Sinh – Địa
- B03: Toán – Sinh – Văn
- B04: Toán – Sinh – GDCD
- B05: Toán – Hóa – Lý
- B08: Toán – Sinh – Anh
Sự mở rộng này giúp thí sinh có nhiều lựa chọn hơn, không chỉ giới hạn trong ngành Y Dược mà còn mở rộng sang Khoa học Môi trường, Công nghệ Sinh học, Công nghệ Thực phẩm, Thú y,... Chương trình mới chú trọng giáo dục STEM, giúp học sinh phát triển tư duy khoa học và ứng dụng thực tiễn tốt hơn trong các môn như Sinh học, Hóa học. Sựu thay đổi này cũng tăng tính linh hoạt trong việc lựa chọn môn học khi thí sinh có thể lựa chọn tổ hợp phù hợp với thế mạnh của mình, thay vì bắt buộc theo khối B truyền thống. Điều này giúp tăng cơ hội trúng tuyển vào các ngành Y Dược, Công nghệ Sinh học, Môi trường…Với sự xuất hiện của tổ hợp B08 (Toán – Sinh – Anh), nhiều trường ưu tiên xét tuyển thí sinh có nền tảng ngoại ngữ tốt, phù hợp với xu hướng hội nhập quốc tế trong lĩnh vực Y học, Công nghệ Sinh học.
Tại sao khối B vẫn là lựa chọn hấp dẫn đối với thí sinh?
Khối B vẫn thu hút lượng lớn thí sinh mỗi năm nhờ cơ hội việc làm rộng mở và mức lương hấp dẫn trong nhiều ngành nghề. Theo thống kê của Bộ Giáo dục & Đào tạo năm 2024, có khoảng 250.000 thí sinh đăng ký xét tuyển các ngành thuộc khối B, chiếm khoảng 20% tổng số thí sinh thi đại học. Lý do chính là các ngành thuộc khối B như Y Dược, Công nghệ Sinh học, Công nghệ Thực phẩm, Khoa học Môi trường đều có nhu cầu nhân lực cao và xu hướng phát triển mạnh mẽ.
? Ngành Y Dược luôn là ngành "hot" với tỷ lệ việc làm lên đến 95% sau khi tốt nghiệp. Theo báo cáo của Bộ Y tế, Việt Nam cần bổ sung khoảng 55.000 bác sĩ và 83.000 điều dưỡng viên đến năm 2030 để đáp ứng nhu cầu chăm sóc sức khỏe dân số. Điều này khiến ngành Y Dược trở thành lựa chọn hàng đầu cho thí sinh muốn có công việc ổn định và thu nhập cao.
? Ngành Công nghệ Sinh học đang tăng trưởng mạnh mẽ, đặc biệt trong lĩnh vực y học và nông nghiệp công nghệ cao. Theo số liệu từ Cục Thống kê Lao động, nhu cầu tuyển dụng trong ngành này tăng khoảng 20% mỗi năm, với mức lương khởi điểm từ 8 - 20 triệu đồng/tháng tùy vị trí.
? Ngành Công nghệ Thực phẩm cũng rất tiềm năng, khi thị trường thực phẩm và đồ uống tại Việt Nam đạt quy mô hơn 40 tỷ USD vào năm 2024, thúc đẩy nhu cầu tuyển dụng kỹ sư thực phẩm tại các tập đoàn lớn như Vinamilk, Masan, Nestlé.

Nhờ vào tiềm năng việc làm, mức thu nhập ổn định và nhu cầu nhân lực cao, khối B vẫn là lựa chọn hàng đầu của thí sinh mỗi năm.
2. Danh Sách Các Ngành Thuộc Khối B
Khối B chủ yếu tập trung vào các ngành liên quan đến Y Dược, Sinh học, Công nghệ, Nông – Lâm – Ngư nghiệp, Khoa học Môi trường. Dưới đây là danh sách cụ thể các ngành:
? Nhóm ngành Y Dược:
- Y khoa
- Răng – Hàm – Mặt
- Dược học
- Điều dưỡng
- Xét nghiệm Y học
- Y học cổ truyền
- Y tế công cộng
- Hộ sinh
- Kỹ thuật hình ảnh Y học

? Nhóm ngành Khoa học Sinh học – Môi trường:
- Công nghệ Sinh học
- Khoa học Môi trường
- Quản lý Tài nguyên Môi trường
- Kỹ thuật Môi trường
- Địa lý tự nhiên

? Nhóm ngành Nông – Lâm – Ngư nghiệp:
- Chăn nuôi
- Thú y
- Bảo vệ thực vật
- Khoa học cây trồng
- Kinh tế Nông nghiệp
- Nuôi trồng thủy sản
- Lâm nghiệp

? Nhóm ngành Công nghệ – Kỹ thuật:
- Công nghệ Thực phẩm
- Kỹ thuật Hóa học
- Công nghệ Sinh học ứng dụng

? Nhóm ngành Kinh tế – Quản lý (có tuyển khối B ở một số trường):
- Quản lý Đất đai
- Kinh tế Tài nguyên
- Kinh tế Nông nghiệp

3. Ngành Khối B Nào Dễ Xin Việc Nhất?
Khi chọn ngành học, ngoài sở thích và năng lực cá nhân, thí sinh cần quan tâm đến nhu cầu thị trường lao động để đảm bảo cơ hội việc làm sau khi tốt nghiệp. Dưới đây là những ngành thuộc khối B có tiềm năng xin việc cao nhất hiện nay.
3.1 Ngành Y Dược
Y Dược là nhóm ngành có nhu cầu tuyển dụng cao và mức lương hấp dẫn nhất trong khối B. Sự phát triển của xã hội kéo theo nhu cầu chăm sóc sức khỏe tăng mạnh, khiến nguồn nhân lực ngành Y Dược chưa bao giờ đủ. Theo thống kê của Bộ Y tế, Việt Nam vẫn đang thiếu hàng nghìn bác sĩ, dược sĩ, điều dưỡng viên mỗi năm, đặc biệt là tại các vùng nông thôn, miền núi.
? Các ngành tiêu biểu trong nhóm Y Dược:
- Bác sĩ Đa khoa, Răng – Hàm – Mặt, Y học cổ truyền: Cần thời gian đào tạo dài nhưng cơ hội việc làm ổn định, mức lương cao.
- Dược học: Làm việc tại bệnh viện, công ty dược phẩm, hoặc mở nhà thuốc riêng.
- Điều dưỡng, Kỹ thuật Xét nghiệm Y học, Kỹ thuật Hình ảnh Y học: Đang có nhu cầu cao tại bệnh viện và phòng khám tư nhân.

? Cơ hội việc làm:
- Làm việc tại bệnh viện công/tư, trung tâm y tế, viện nghiên cứu, công ty dược.
- Xu hướng xuất khẩu điều dưỡng sang các nước như Đức, Nhật Bản, Hàn Quốc mang lại cơ hội việc làm rộng mở.
? Mức lương trung bình:
- Sinh viên mới ra trường: 8-15 triệu/tháng.
- Bác sĩ có kinh nghiệm: 30-50 triệu/tháng.
- Dược sĩ mở nhà thuốc: Thu nhập không giới hạn, tùy vào khả năng kinh doanh.
3.2 Ngành Công Nghệ Sinh Học
Công nghệ Sinh học là một trong những ngành đang được chú trọng phát triển tại Việt Nam, ứng dụng rộng rãi trong y học, nông nghiệp, thực phẩm, mỹ phẩm và cả bảo vệ môi trường. Nhiều doanh nghiệp lớn như Vinamilk, Masan, TH True Milk, Abbott, Ajinomoto, Tập đoàn L’Oréal... đang đầu tư mạnh vào nghiên cứu và phát triển sản phẩm ứng dụng Công nghệ Sinh học.
? Các lĩnh vực ứng dụng Công nghệ Sinh học:
- Y dược: Nghiên cứu sản xuất vaccine, sinh phẩm y tế (như vaccine COVID-19).
- Nông nghiệp: Nhân giống cây trồng, phát triển giống biến đổi gen có năng suất cao.
- Công nghệ thực phẩm: Ứng dụng vi sinh vật để sản xuất thực phẩm chức năng, sữa chua, men vi sinh.
- Môi trường: Sử dụng vi sinh để xử lý rác thải, nước thải công nghiệp.

? Cơ hội việc làm:
- Làm việc tại các phòng thí nghiệm, viện nghiên cứu, công ty sản xuất thực phẩm và mỹ phẩm.
- Cơ hội làm việc tại nước ngoài hoặc các tổ chức quốc tế về công nghệ sinh học.
? Mức lương trung bình:
- Sinh viên mới ra trường: 8-12 triệu/tháng.
- Chuyên viên nghiên cứu: 15-25 triệu/tháng.
- Giám đốc phòng thí nghiệm hoặc quản lý sản xuất: 30-50 triệu/tháng.
3.3 Ngành Khoa Học Môi Trường & Quản Lý Tài Nguyên
Trước tình trạng biến đổi khí hậu và ô nhiễm môi trường ngày càng nghiêm trọng, các công ty, tập đoàn và chính phủ đang đầu tư mạnh vào lĩnh vực bảo vệ môi trường và quản lý tài nguyên thiên nhiên. Theo báo cáo của Liên Hợp Quốc, ngành công nghiệp môi trường sẽ cần thêm hàng triệu lao động trong những năm tới.
? Các chuyên ngành thuộc nhóm này:
- Kỹ thuật môi trường: Xử lý nước thải, rác thải, ô nhiễm không khí.
- Quản lý tài nguyên thiên nhiên: Nghiên cứu, đánh giá và bảo tồn đa dạng sinh học.
- Công nghệ sinh học môi trường: Ứng dụng vi sinh để xử lý chất thải.
? Cơ hội việc làm:
- Làm việc tại các công ty tư vấn môi trường, tập đoàn năng lượng tái tạo, các tổ chức phi chính phủ (WWF, UNESCO,...).
- Làm việc trong các sở tài nguyên môi trường, viện nghiên cứu về môi trường.
? Mức lương trung bình:
- Sinh viên mới ra trường: 7-12 triệu/tháng.
- Chuyên gia môi trường có kinh nghiệm: 15-25 triệu/tháng.
3.4 Ngành Thú Y & Chăn Nuôi
Ngành Thú Y không chỉ gói gọn trong việc chăm sóc vật nuôi mà còn đóng vai trò quan trọng trong kiểm soát dịch bệnh, sản xuất thực phẩm sạch và công nghệ chăn nuôi công nghiệp.
? Lý do ngành Thú Y có nhu cầu cao:
- Sự phát triển mạnh mẽ của ngành chăn nuôi gia súc, gia cầm tại Việt Nam.
- Số lượng thú cưng ngày càng tăng, kéo theo nhu cầu bác sĩ thú y tăng cao.
- Xu hướng xuất khẩu lao động bác sĩ thú y sang Nhật Bản, Úc, Canada.

? Cơ hội việc làm:
- Làm việc tại các trang trại chăn nuôi quy mô lớn (CP Group, Dabaco, GreenFeed,...).
- Làm việc tại các phòng khám thú y, bệnh viện thú y.
- Cơ hội mở phòng khám thú y riêng, thu nhập cao.
? Mức lương trung bình:
- Bác sĩ thú y mới ra trường: 8-12 triệu/tháng.
- Mở phòng khám thú y: 30 triệu/tháng trở lên.
3.5 Ngành Công Nghệ Thực Phẩm
Công nghệ Thực phẩm là ngành chưa bao giờ lỗi thời bởi nhu cầu tiêu dùng thực phẩm an toàn và chất lượng ngày càng cao. Hầu hết các công ty thực phẩm lớn tại Việt Nam như Vinamilk, Masan, Nestlé, Ajinomoto đều có nhu cầu tuyển dụng nhân sự ngành này.
? Công việc trong ngành Công nghệ Thực phẩm:
- Nghiên cứu, phát triển sản phẩm mới (sữa, bánh kẹo, thực phẩm chức năng,...).
- Đảm bảo an toàn vệ sinh thực phẩm trong quy trình sản xuất.
- Quản lý chất lượng thực phẩm tại các nhà máy chế biến.

? Cơ hội việc làm:
- Làm việc tại các công ty sản xuất thực phẩm lớn.
- Cơ hội xuất khẩu lao động sang Nhật Bản, Hàn Quốc.
? Mức lương trung bình:
- Sinh viên mới ra trường: 7-12 triệu/tháng.
- Kỹ sư thực phẩm có kinh nghiệm: 15-25 triệu/tháng.
Tóm lại, ngành nào dễ xin việc nhất? Nếu xét về mức lương cao và cơ hội phát triển lâu dài, ngành Y Dược vẫn là lựa chọn hàng đầu. Tuy nhiên, nếu bạn muốn tìm ngành có tính ứng dụng rộng và cơ hội việc làm đa dạng, thì Công nghệ Sinh học, Công nghệ Thực phẩm, Khoa học Môi trường và Thú Y cũng là những lựa chọn đáng cân nhắc.
4. Cơ Hội Việc Làm Và Mức Lương Của Các Ngành Khối B
4. 1. Ngành Y Dược – Cơ Hội Việc Làm Ổn Định, Mức Lương Cao
Ngành Y Dược luôn là lựa chọn hàng đầu với những ai muốn có công việc ổn định và thu nhập cao. Đây là lĩnh vực thiết yếu trong xã hội, luôn có nhu cầu nhân lực lớn do nhu cầu chăm sóc sức khỏe ngày càng tăng.
? Cơ hội việc làm:
- Làm việc tại các bệnh viện công và tư, phòng khám đa khoa, trung tâm y tế.
- Làm trong các công ty dược phẩm lớn như Sanofi, DHG Pharma, Traphaco, Mekophar.
- Nghiên cứu tại các viện khoa học y tế hoặc giảng dạy tại các trường đại học.
- Xu hướng xuất khẩu lao động điều dưỡng, bác sĩ sang Nhật Bản, Đức, Úc với mức lương cao.
? Mức lương tham khảo:
- Bác sĩ, dược sĩ mới ra trường: 8-15 triệu/tháng.
- Dược sĩ làm tại công ty dược: 10-20 triệu/tháng (tùy vị trí).
- Bác sĩ có kinh nghiệm trên 5 năm: 30-50 triệu/tháng.
- Dược sĩ mở nhà thuốc: Thu nhập có thể lên đến 50-100 triệu/tháng.
? Thực tế: Tại các thành phố lớn như TP.HCM và Hà Nội, bác sĩ giỏi có thể kiếm hơn 100 triệu/tháng nếu mở phòng khám riêng hoặc làm thêm ngoài giờ.

4. 2. Ngành Công Nghệ Sinh Học – Tiềm Năng Phát Triển Trong Tương Lai
Công nghệ Sinh học là ngành có ứng dụng rộng trong y tế, nông nghiệp, thực phẩm, môi trường, tạo ra nhiều cơ hội việc làm. Với sự phát triển của khoa học và công nghệ, lĩnh vực này ngày càng được đầu tư mạnh mẽ tại Việt Nam và thế giới.
? Cơ hội việc làm:
- Làm việc tại các viện nghiên cứu sinh học, công ty sản xuất vaccine, công ty chế phẩm sinh học.
- Làm việc tại các tập đoàn lớn như Vinamilk, Masan, Abbott, Ajinomoto, Nestlé.
- Ứng dụng công nghệ sinh học trong chế biến thực phẩm, mỹ phẩm, dược phẩm.
? Mức lương tham khảo:
- Sinh viên mới ra trường: 8-12 triệu/tháng.
- Chuyên viên nghiên cứu tại các tập đoàn: 15-20 triệu/tháng.
- Trưởng phòng nghiên cứu hoặc chuyên gia có kinh nghiệm: 30-50 triệu/tháng.
? Thực tế: Theo báo cáo của Viện Công Nghệ Sinh Học Việt Nam, nhu cầu nhân lực ngành này tăng trung bình 20% mỗi năm, đặc biệt là trong lĩnh vực y sinh và dược phẩm.

4.3. Ngành Môi Trường – Nghề Xanh, Xu Hướng Phát Triển Bền Vững
Biến đổi khí hậu, ô nhiễm môi trường và nhu cầu phát triển bền vững đang khiến ngành Khoa học Môi trường trở thành một trong những ngành hot trong tương lai. Chính phủ và các doanh nghiệp ngày càng quan tâm đến bảo vệ môi trường, mở ra nhiều cơ hội nghề nghiệp hấp dẫn.
? Cơ hội việc làm:
- Làm việc tại các sở tài nguyên môi trường, viện nghiên cứu môi trường.
- Làm việc trong các công ty xử lý nước thải, rác thải công nghiệp như Heineken, Unilever, Coca-Cola.
- Làm tại các tổ chức phi chính phủ (WWF, UNESCO) về môi trường.
? Mức lương tham khảo:
- Sinh viên mới ra trường: 7-12 triệu/tháng.
- Chuyên viên môi trường có kinh nghiệm: 12-20 triệu/tháng.
- Quản lý dự án môi trường hoặc chuyên gia: 25-40 triệu/tháng.
? Thực tế: Các công ty lớn đang ngày càng siết chặt quy trình sản xuất để đảm bảo tiêu chuẩn môi trường, tạo ra nhiều cơ hội cho kỹ sư môi trường.

4.4. Ngành Công Nghệ Thực Phẩm – Ngành Chưa Bao Giờ Lỗi Thời
Công nghệ Thực phẩm là một trong những ngành có nhu cầu nhân lực ổn định nhất. Thực phẩm là nhu cầu thiết yếu, nên doanh nghiệp sản xuất thực phẩm luôn tìm kiếm nhân sự có chuyên môn để đảm bảo chất lượng sản phẩm.
? Cơ hội việc làm:
- Làm việc tại các công ty thực phẩm lớn như Vinamilk, Nestlé, Masan, Pepsi, Kinh Đô.
- Đảm nhiệm các vị trí kiểm định chất lượng thực phẩm, nghiên cứu phát triển sản phẩm.
- Làm việc tại các phòng thí nghiệm an toàn thực phẩm hoặc bộ phận quản lý chất lượng (QA, QC) của doanh nghiệp sản xuất thực phẩm.
? Mức lương tham khảo:
- Sinh viên mới ra trường: 7-12 triệu/tháng.
- Chuyên viên R&D (nghiên cứu & phát triển sản phẩm): 12-18 triệu/tháng.
- Quản lý sản xuất hoặc chuyên gia kiểm định thực phẩm: 20-40 triệu/tháng.
? Thực tế: Các công ty thực phẩm có quy trình sản xuất khép kín, yêu cầu nghiêm ngặt về chất lượng nên rất cần nhân lực có chuyên môn cao.

5. Danh Sách Các Trường Đại Học Đào Tạo Khối B Uy Tín
? Miền Bắc:
- Đại học Y Hà Nội
- Đại học Dược Hà Nội
- Đại học Khoa học Tự nhiên – ĐHQG Hà Nội
- Học viện Nông nghiệp Việt Nam
? Miền Trung:
- Đại học Y Dược Huế
- Đại học Nông Lâm Huế
- Đại học Bách Khoa Đà Nẵng
? Miền Nam:
- Đại học Y Dược TP.HCM
- Đại học Khoa học Tự nhiên – ĐHQG TP.HCM
- Đại học Nông Lâm TP.HCM
6. Kinh Nghiệm Chọn Ngành Khối B Phù Hợp Với Bản Thân
Lựa chọn ngành học là một quyết định quan trọng, ảnh hưởng trực tiếp đến tương lai sự nghiệp. Với khối B, có nhiều ngành nghề hấp dẫn, nhưng không phải ai cũng biết cách chọn ngành phù hợp. Để lựa chọn ngành trong khối B bạn cần xác định những đặc điểm sau:
Xác định sở thích và thế mạnh cá nhân
Một trong những yếu tố quan trọng nhất khi chọn ngành học là sở thích và thế mạnh của bản thân. Nếu bạn yêu thích công việc liên quan đến con người, thích khám phá cơ thể con người và mong muốn giúp đỡ người khác, ngành Y Dược sẽ là lựa chọn phù hợp.
? Ví dụ
- Nếu bạn có tính kiên nhẫn, tỉ mỉ và đam mê cứu chữa bệnh nhân, hãy chọn ngành Bác sĩ, Điều dưỡng, Dược học.
- Nếu bạn thích nghiên cứu khoa học, làm việc trong phòng thí nghiệm, ngành Công nghệ Sinh học có thể phù hợp hơn.
- Nếu bạn quan tâm đến các vấn đề về môi trường, bảo vệ thiên nhiên, ngành Khoa học Môi trường sẽ là lựa chọn lý tưởng.
- Nếu bạn yêu thích ẩm thực, muốn làm việc trong lĩnh vực kiểm định chất lượng thực phẩm, ngành Công nghệ Thực phẩm là một hướng đi tốt.
? Lời khuyên: Trước khi chọn ngành, hãy thử làm các bài trắc nghiệm tính cách nghề nghiệp (như Holland Code, MBTI) để hiểu rõ bản thân phù hợp với ngành nào.
Tìm hiểu về nhu cầu thị trường lao động
Chọn một ngành có đam mê là điều quan trọng, nhưng bạn cũng cần quan tâm đến xu hướng thị trường lao động. Ngành đó có dễ xin việc không? Mức lương có ổn định không? Cơ hội thăng tiến như thế nào?
? Dữ liệu thị trường thực tế:
- Ngành Y Dược: Luôn có nhu cầu cao, đặc biệt là bác sĩ, dược sĩ, điều dưỡng. Mức lương hấp dẫn, dễ xin việc nhưng áp lực lớn.
- Ngành Công nghệ Sinh học: Đang phát triển mạnh trong lĩnh vực y học, dược phẩm, nông nghiệp công nghệ cao. Nhu cầu tuyển dụng tăng khoảng 20% mỗi năm.
- Ngành Môi trường: Được chính phủ và các doanh nghiệp quan tâm hơn do xu hướng phát triển bền vững. Cơ hội làm việc tại các công ty đa quốc gia như Unilever, Nestlé.
- Ngành Công nghệ Thực phẩm: Thực phẩm là nhu cầu thiết yếu, các công ty thực phẩm lớn luôn cần nhân sự chất lượng cao, mức lương ổn định.
? Lời khuyên: Hãy tìm hiểu về tỷ lệ việc làm của ngành sau khi tốt nghiệp thông qua các báo cáo của Bộ GD&ĐT, các diễn đàn nghề nghiệp hoặc khảo sát từ cựu sinh viên
Chọn trường đại học phù hợp với năng lực và điều kiện tài chính
Trường đại học không chỉ ảnh hưởng đến chất lượng đào tạo mà còn quyết định mạng lưới quan hệ, cơ hội thực tập, khả năng xin việc sau khi ra trường. Khi chọn trường, bạn cần cân nhắc chất lượng đào tạo, học phí, cơ sở vật chất và chương trình liên kết doanh nghiệp.
? Một số trường đại học đào tạo tốt các ngành khối B:
✅ Ngành Y Dược:
- Đại học Y Hà Nội, Đại học Y Dược TP.HCM: Chương trình đào tạo chất lượng cao, đầu vào khó, có nhiều cơ hội việc làm sau tốt nghiệp.
- Đại học Dược Hà Nội, Đại học Y Dược Huế: Nổi bật trong đào tạo Dược học.
✅ Ngành Công nghệ Sinh học:
- Đại học Khoa học Tự nhiên (ĐHQG Hà Nội & TP.HCM), Học viện Nông nghiệp Việt Nam: Đào tạo chuyên sâu về Công nghệ Sinh học ứng dụng.
✅ Ngành Môi trường:
- Đại học Bách Khoa Hà Nội, Đại học Khoa học Tự nhiên TP.HCM: Đào tạo bài bản về Kỹ thuật môi trường.
- Đại học Tài nguyên và Môi trường: Có chương trình đào tạo thực tế, thực tập tại các doanh nghiệp.
✅ Ngành Công nghệ Thực phẩm:
- Đại học Bách Khoa TP.HCM, Đại học Nông Lâm TP.HCM: Nổi tiếng về đào tạo ngành Công nghệ Thực phẩm.
- Đại học Công nghiệp Thực phẩm TP.HCM: Chương trình giảng dạy kết hợp thực hành, dễ xin việc sau khi ra trường.
? Lời khuyên: Nếu tài chính hạn chế, có thể cân nhắc các trường có mức học phí thấp hơn hoặc có chương trình học bổng để hỗ trợ chi phí học tập.
Để chọn ngành khối B phù hợp, bạn cần kết hợp đam mê cá nhân, thế mạnh bản thân, cơ hội việc làm và chất lượng đào tạo của trường đại học. Không có ngành nào là tốt nhất, chỉ có ngành phù hợp nhất với bạn!
? Hành động ngay hôm nay:
✅ Làm trắc nghiệm nghề nghiệp để hiểu rõ bản thân.
✅ Tìm hiểu về nhu cầu lao động của từng ngành.
✅ Chọn trường đại học có chất lượng đào tạo tốt.
7. Kết Luận
Khối B mang đến nhiều cơ hội nghề nghiệp trong các lĩnh vực Y tế, Sinh học, Môi trường, Nông nghiệp. Những ngành dễ xin việc nhất hiện nay thường thuộc Y Dược, Công nghệ Sinh học, Công nghệ Thực phẩm và Môi trường. Tuy nhiên, để có một sự nghiệp vững chắc, thí sinh cần lựa chọn ngành học dựa trên sở thích cá nhân, năng lực và xu hướng thị trường lao động.
Xem thêm các bài viết cùng chủ đề:
Học Khối A thi ngành gì? Top 10 Ngành hot & dễ xin việc nhất
Khối A1 Gồm Những Ngành Nào? Danh Sách Ngành Học, Điểm Chuẩn & Cơ Hội Việc Làm 2025
Khối D gồm những ngành học nào? Ra trường làm gì? - Cập nhật mới nhất
Khối D07 gồm những ngành học nào? Học D07 có thi ngành dược được không?
